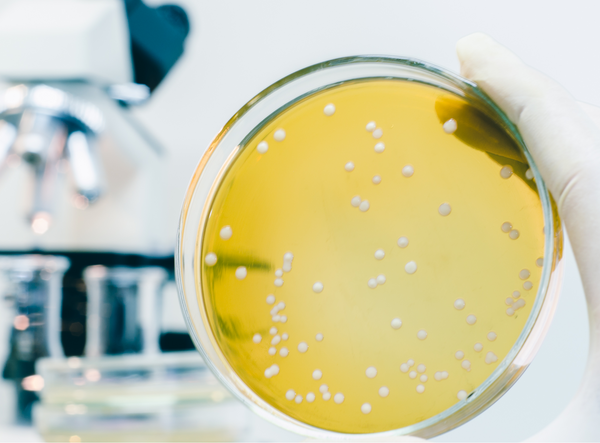

Your satisfaction is our top priority. That is why we use cookies
to ensure the secure and reliable operation of our website, to
analyze its performance, and to tailor our content to your needs
as effectively as possible.
Cookies are necessary for our website to function properly and to display
external content. We also collect data, for example, on pages visited,
purchases made, and buttons clicked, to continuously improve our services for you.
With your consent, we use cookies and mobile advertising IDs to provide personalized
and non-personalized advertising ("ad personalization") and to measure its effectiveness.
This is voluntary and not required to use the website.
Google may process your personal data in accordance with Google's Business Safety & Privacy Terms. More information about how Google uses data can be found here: https://business.safety.google/privacy
You can find more information about the services we use in the "Advanced Settings" and in our Privacy Policy.
By clicking "Accept All," you consent to the use of these services. You can
change or withdraw your consent at any time going forward by clicking "Cookie Policy" in the footer.
Here, you can select which categories of cookies you wish to allow (Art. 6(1)(a) GDPR, consent). Technically required cookies are necessary for the website to function and cannot be disabled (Art. 6(1)(f) GDPR, legitimate interest).
Essential
Essential cookies enable basic functions and are necessary for the website to work properly.
Statistics
Statistics cookies collect information anonymously. This information helps us understand how our visitors use our website.
Marketing
Marketing cookies are used by third-party providers or publishers to display personalized ads. They do this by tracking visitors across websites.